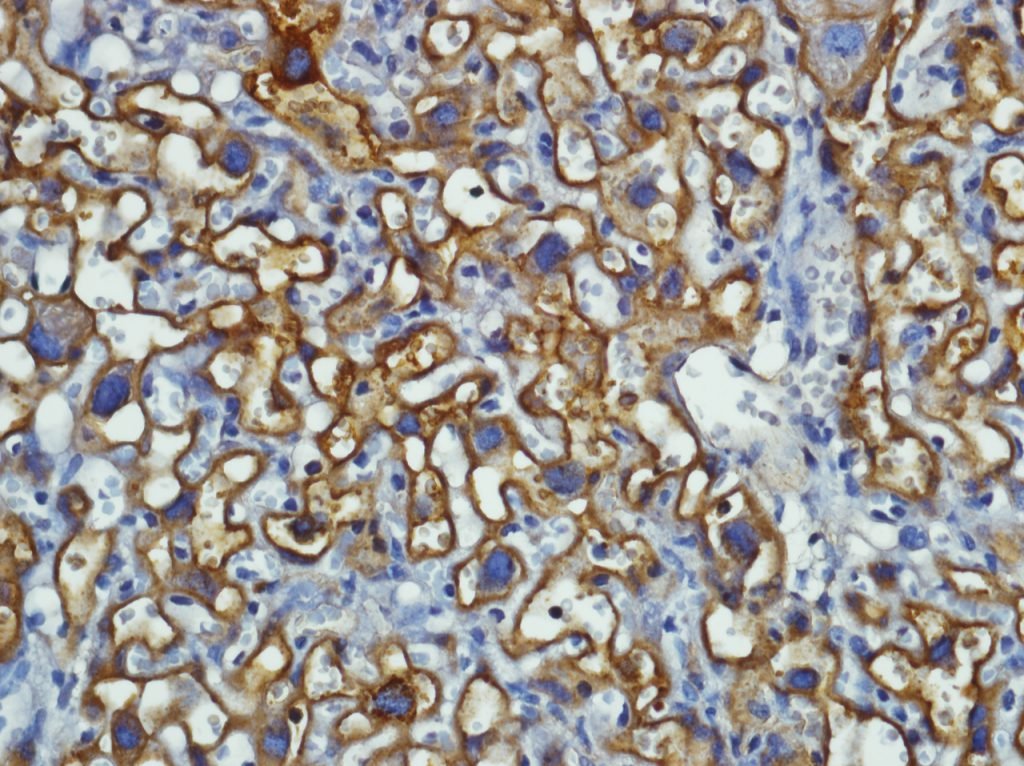

As duas substâncias que se alteram quando a placenta inflama e podem desencadear partos prematuros
Tania Maria Ruffoni Ortiga

Entre as diversas proteínas do nosso organismo, os chamados transportadores ABC (ATP-Binding Cassette) estão entre os mais importantes. Presentes desde bactérias a seres humanos, esses transportadores ficam na membrana das células, transportando diversas substâncias para dentro e para fora delas. Entre elas, estão sais biliares, colesterol e algumas drogas. Durante a gravidez, eles funcionam como verdadeiros portões na placenta, controlando e retirando toxinas ao redor do feto e as devolvendo para a mãe, com o objetivo de proteger o bebê de substâncias nocivas.
Um primeiro mapeamento realizado pela equipe do projeto mostra que, na ocorrência de parto prematuro, cerca de 30 desses transportadores sofrem algum tipo de alteração. “Eles são tão fundamentais que existem em grande quantidade para haver uma sobreposição: se faltar ou diminuir um, outro já entra em ação para compensar”, explica a pesquisadora Tania Maria Ruffoni Ortiga, Professora Titular e chefe do Laboratório de Endocrinologia Translacional do Instituto de Biofísica Carlos Chagas Filho da Universidade Federal do Rio de Janeiro (UFRJ). “Decidimos focar nos dois que mais se alteram num parto antes do tempo, o PGP (glicoproteína-P) e BCRP (Breast Cancer Resistance Protein ou Proteína de Resistência do Câncer de Mama) para verificar se existiam elementos comuns entre eles e determinar se eles seriam biomarcadores que pudessem indicar prematuridade”.
O objetivo do estudo foi avaliar como diferentes tipos de infecções alteram os transportadores ABC e se essa alteração poderia ser um dos desencadeadores ou fator coadjuvante para o parto prematuro. Para isso, a equipe utilizou modelos de placentas de camundongos fêmeas infectadas por malária, bactéria e vírus da Zika. No último caso, foi possível pesquisar também a presença dos transportadores em placenta humana. Em todas as situações, os pesquisadores observaram que houve diminuição desses dois transportadores na membrana das células da placenta. “Isso é bom ou ruim? É para preservar o feto ou leva a um acúmulo de toxinas que desencadeiam o parto antes do tempo? Ainda não sabemos e precisamos de mais estudos”, afirma Tânia.
O PGP transporta antibióticos, antivirais e antiparasitários. Em geral, ele retira medicamentos e substâncias tóxicas que podem passar para o feto. Isso pode ser um problema nos casos em que um medicamento precisa chegar até o bebê. Já o BCRP está ligado ao transporte de ácido fólico. “Quando ele aumenta demais, pode ser prejudicial”, afirma Tânia. “Não sabemos ainda se a diminuição desses dois transportadores contribui para causar o parto prematuro ou se fazem parte de um mecanismo que tenta evitá-lo”. Para responder essa questão será preciso continuar os estudos, idealmente com animais transgênicos para se manipular artificialmente a resposta, ou expressão, desses transportadores na placenta e avaliar os efeitos de sua inibição ou alta estimulação no desencadeamento de parto prematuro. Também seria possível obter os mesmos efeitos com alguns medicamentos, segundo os pesquisadores.
Para além dos resultados científicos da pesquisa básica, importantes para a continuidade de outros estudos, o projeto teve alguns efeitos colaterais positivos também. Por causa dele, um dos membros da equipe, o pesquisador Enrrico Bloise, da Universidade Federal de Minas Gerais (UFMG) passou a ser professor na universidade e a derivar todos os seus primeiros trabalhos desta pesquisa. Além disso, Tânia conseguiu criar um biotério, local onde animais são conservados para que sejam posteriormente utilizados em experimentos científicos, em seu laboratório e também uma nova linha de pesquisa sobre a influência dos transportadores ABC na placenta. “O Grand Challenges mudou minha carreira e meu jeito de fazer ciência”, diz ela.

